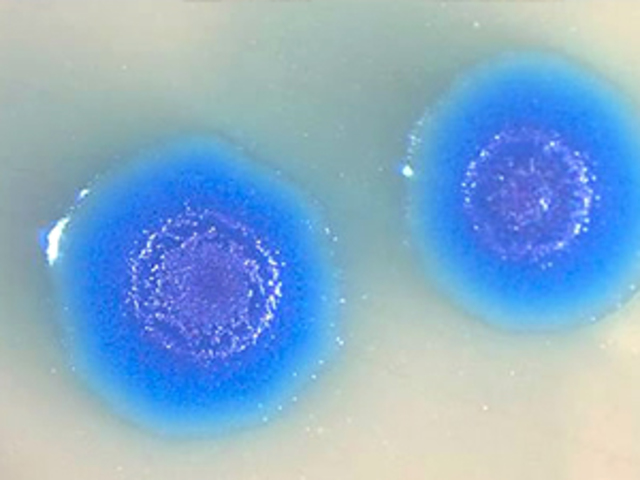
célula artificial

-
Gregor Mendel descubrió las leyes de la herencia genética, hoy llamadas leyes de Mendel.
-
El medico y biologo Friedrich Miescher descubre la nucleina, sustancia que posteriormente se llamara, ácidos nucleicos.
-
El medico Richard Altmann a través de técnicas fisico-quimicas logra dividir a la nucleina en pequeñas partes y las nombra ácidos nucleicos.
-
El químico alemán Robert Feulgen describió un método para teñir el ADN por medio de un colorante llamado fucsina.
-
El bioquímico Phoebus Levene determino los componentes de los acidos nucleicos: azúcar y bases nitrogenadas.
-
Levene y Kossel probaron que la nucleina de miescher es un ácido desoxirribonucleico formado por: 4 bases nitrogenadas, azúcar desoxirribosa y un grupo fosfato.
-
Hammarsten y Caspersson descubren que el ADN es un polímero.
-
A. N. Belozersky extrae ADN de plantas y demuestra que estas tienen los 2 tipos de ácidos nucleicos (ADN y ARN).
-
Oswald Avery publicó que la herencia genética reside en el ADN.
-
Erwin Chargaff publica su observación sobre la composición del ADN y da dos reglas sobre las bases nitrogenadas: A+G= T+C
-
Los químicos Pauling y Corey proponen las estructuras de hélice alfa y hoja plegada beta en las proteínas.
-
Frederick Sanger determina la secuencia aminoacídica de la insulina.
-
El profesor Vernon Ingram descubre que la anemia falciforme es causada por el cambio de un aminoácido en la hemoglobina.
-
Se demuestra por Meselson y Stahl, que la replicación del ADN es semiconservativa.
-
Arthur Kornberg aísla la ADN polimerasa I.
-
Hurwitz y Weiss descubren el ARN polimerasa.
-
Kendrew y Perutz descifran la estructura tridimensional de las proteínas hemoglobina y mioglobina.
-
Spiegelman desarrolló la técnica de hibridación de ácidos nucleicos.
-
Robert W. Holley determina en su laboratorio la primera secuencia de un ARN.
-
Berg y Boyer preparan la primera molécula de ADN recombinante usando enzimas de restricción y con esto consiguen la primera clonación exitosa.
-
Maxam y Gilbert desarrollan técnica para secuenciar ácidos nucleicos de manera química.
-
Los doctores Milstein y Kohler del laboratorio de biologia molecular de la univ. de cambridge descubren los anticuerpos.
-
Se funda Genentech, primera empresa de ingeniería genética.
Síntesis de la hormona del crecimiento obtenida artificialmente, para el tratamiento del enanismo. -
El biólogo David Botstein Después de usar las enzimas de restricción descubre los RFLP.
-
Kary Mullis crea la técnica PCR, que permite replicar genes específicos. esto permite el inicio de la era de la terapia genética.
-
Sale al mercado en Estados Unidos, el primer medicamento producido por manipulación genética (insulina).
-
Se inicia oficialmente el proyecto genoma humano (PGH), destinado a descifrar el código genético humano.
-
Por primera vez se clonan embriones humanos pero el expermiento no tiene exito.
-
Clonación de la oveja Dolly.
-
Publican primer borrador del genoma humano.
-
Se publica la primera versión culminada del genoma humano.
-
Celera Genomics de Craig Venter presenta al público la información sobre el genoma humano y comienza el proyecto HapMap.
-
Se hace el primer trasplante de un genoma completo de una bacteria hacia otra bacteria.
-
Se consigue crear un cromosoma sintético por primera vez en la historia a partir de levadura
-
Celera Genomics construye la primera célula artificial.
-
Se logro curar niños con atrofia muscular espinal, se sustituyo el gen defectuoso de las neuronas por uno funcional inyectándoles un virus que contenía la secuencia correcta del gen.
Looking for a timeline maker?
Create timelines for projects, roadmaps, history, lessons, legal cases, and stories with Timetoast. Timetoast is a timeline maker for work, school, research, and stories.